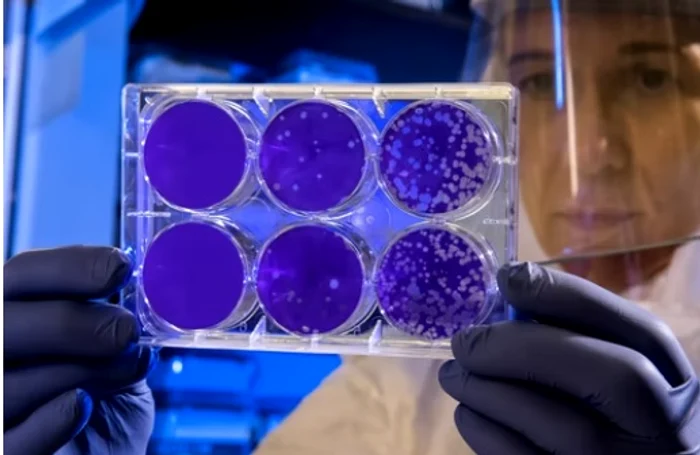
image

Un supervirus ar putea opri pandemia. Temerile oamenilor de știință
Ingineria genetică este atât de dezvoltată în prezent încât oamenii de știință ar putea crea un virus care l-ar putea anihila pe cel care a dus la pandemia de COVID-19.
Experții geneticieni se tem însă să treacă de această ”linie roșie” pentru că nu pot să prevadă dacă nu cumva și acest virus poate dezvolta mutații.
Supervirusul ar putea anihila coronavirusul
Octavian Voiculescu, cercetător român la Cambridge, doctor în embriologie moleculară şi genetică, a explicat într-un interviu pentru Adevărul cum ar putea să pună capăt această variantă artificială a coronavirusului pandemia de COVID-19
Deşi poate să sune aparent SF, oamenii de ştiinţă ar avea capacitatea să „fabrice” o nouă variantă de coronavirus, prin editare genetică, mult mai infecţioasă, dar inofensivă, care să le elimine pe celelalte, dar nimeni nu se încumetă să facă asta.
„Nu poţi să prevezi ce efecte poate avea un virus artificial, chiar dacă el e conceput să îţi rezolve o mică problemă acum. Aşa, la scară mare, SARS-CoV-2 nu este cine ştie ce, nu e prima infecţie zoonotică cu care ne am ales. Nu e cine ştie ce infecţie, nu e ca ciuma bubonică.
E complet neetic la momentul acesta şi motivul e că nu poţi să ştii ce ar face acel virus artificial, dacă mutează. Nu ai nicio siguranţă că nu se va întâmpla lucrul ăsta, oricât de improbabil pare pe hârtie. Dar dacă se întâmplă, nu îşi poate asuma nimeni responsabilitatea asta. Tehnic sigur că se poate. Şi nu e deloc SF”, a explicat cercetătorul.
Voiculescu a mai spus că ”nu prea există o siguranţă că o să dea o imunitate atât de bună împotriva virusului pe care vrei să-l elimini.
Virusul pe care vrei să-l elimini nu avem nicio garanţie că nu o să evolueze şi el şi nu o să producă variante care vor fi mai puţin sensibile la imunitatea pe care ar da-o virusul artificial”.
Pe de altă parte, ” ecologia, inclusiv ecologia virală, nu e deloc o ştiinţă virală. Nu îţi garantează nimeni că merge pe atât de simplu”, a explicat omul de știință.
Precedentul care a ”distrus” un cercetător din motive de etică
Însă, ingineria genetică le permite oamenilor de ştiinţă să acţioneze direct asupra organismului uman, transoformânu-ne în fiinţe invulnerabile în faţa unor virusuri sau bacterii.
În acest caz a fost trecută deja linia roşie şi există un precedent. Un savant chinez a editat genetic doi gemeni pe care i-a făcut să fie rezistenţi la virusul HIV. Deşi omul de ştiinţă se aştepta să fie elogiat şi să devină un model, din motive de etică a fost repudiat, iar întreaga comunitate ştiinţifică i-a întors spatele.
”Riști să dereglezi lucruri mult mai complicate”
Cercetătorul român arată că virusul interacţionează cu gene umane dar oamenii de știință nu vor să atace în această zonă. ”Din câte ştim, virusul se bazează pe produsul unei gene umane. Receptorul acesta ACE2, odată ce a intrat nu mai interacţionează, îşi vede de treaba lui. Ribozomii transcriu ARN-ul viral, aşa cum transcriu orice ARN mesager, se asamblează folosind componente cu totul generice ale unei celule umane. Deci nu prea poţi să ataci acolo. Singurul lucru pe care poţi să-l ataci ar fi gena pentru receptorul prin care virusul pătrunde în celulă.
E un receptor de angiotensină şi în mod natural are de a face cu reglarea tensiunii arteriale. E rolul principal, dar mai are şi alte roluri, iar dacă umbli la ea nu ştii ce faci, că începi să modifici sistemul de reglare a tensiunii, dilatarea vaselor şi aşa mai departe. Intri în nişte chestii complicate pe care nu le poţi controla. În plus, are şi alte efecte fiindcă receptorul asta nu se ocupă numai de asta. Deci nu poţi să modifici doar de dragul de a nu mai intra virusul, rişti să dereglezi lucruri mult mai complicate”, mai spune Voiculescu.
Omul de știință spune că avem la îndemână metodele de a combate pandemia. ”Soluţiile rămân aceleaşi: vaccinarea şi respectarea unui set de reguli deja binecunoscute pentru a preveni infectarea”. De altfel, ultimele studii arată că doza booster, cea de-a treia de vaccin, oferă în continuare protecţie în faţa formelor grave de COVID-19.


































